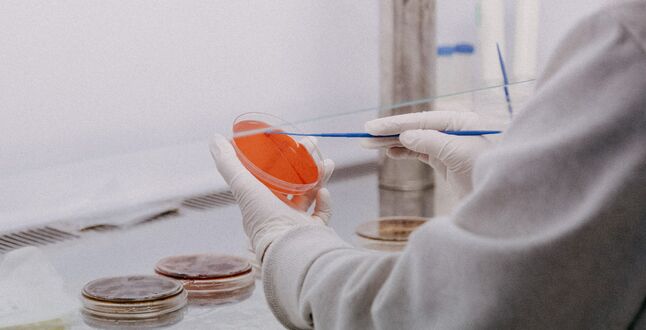

Изучение биоматериала в канализации помогает отслеживать заболеваемость COVID-19 лучше ПЦР-тестов.
Сточные воды становятся важным источником данных об эпидемической ситуации, так как в них обнаруживают геном коронавируса. В этом уверены в администрации водоочистных сооружений во французском городе Пьер-Бенит недалеко от Лиона. Здесь регулярно берут пробы сточных вод для количественного анализа наличия генома коронавируса, пишет Euronews.
По словам экспертов, на основании данных о заражении сточных вод коронавирусом можно на неделю раньше увидеть рост или спад числа инфицированных в том или ином регионе. В этом году образцы из сточных вод во Франции проверяют на наличие новых штаммов коронавируса, — рассказал вирусолог Венсан Марешаль:
«В водах региона Иль-де-Франс/Париж в начале января так называемый "британский штамм" не присутствовал или, по крайней мере, не был обнаружен. Теперь, в последние несколько дней или недель, доля новых разновидностей инфекции растет. Сегодня от 25 до 35% штаммов, выявляемых в сточных водах, имеют специфические мутации».
Похожие национальные программы наблюдения за коронавирусом в сточных водах действуют и в других странах Европы, в частности, в Нидерландах, Италии, Испании, Швейцарии и Люксембурге. В Барселоне, Милане и Турине по анализам из канализации учёные видели начало эпидемии ещё до того, как там были официально зарегистрированы первые случаи заражения.













